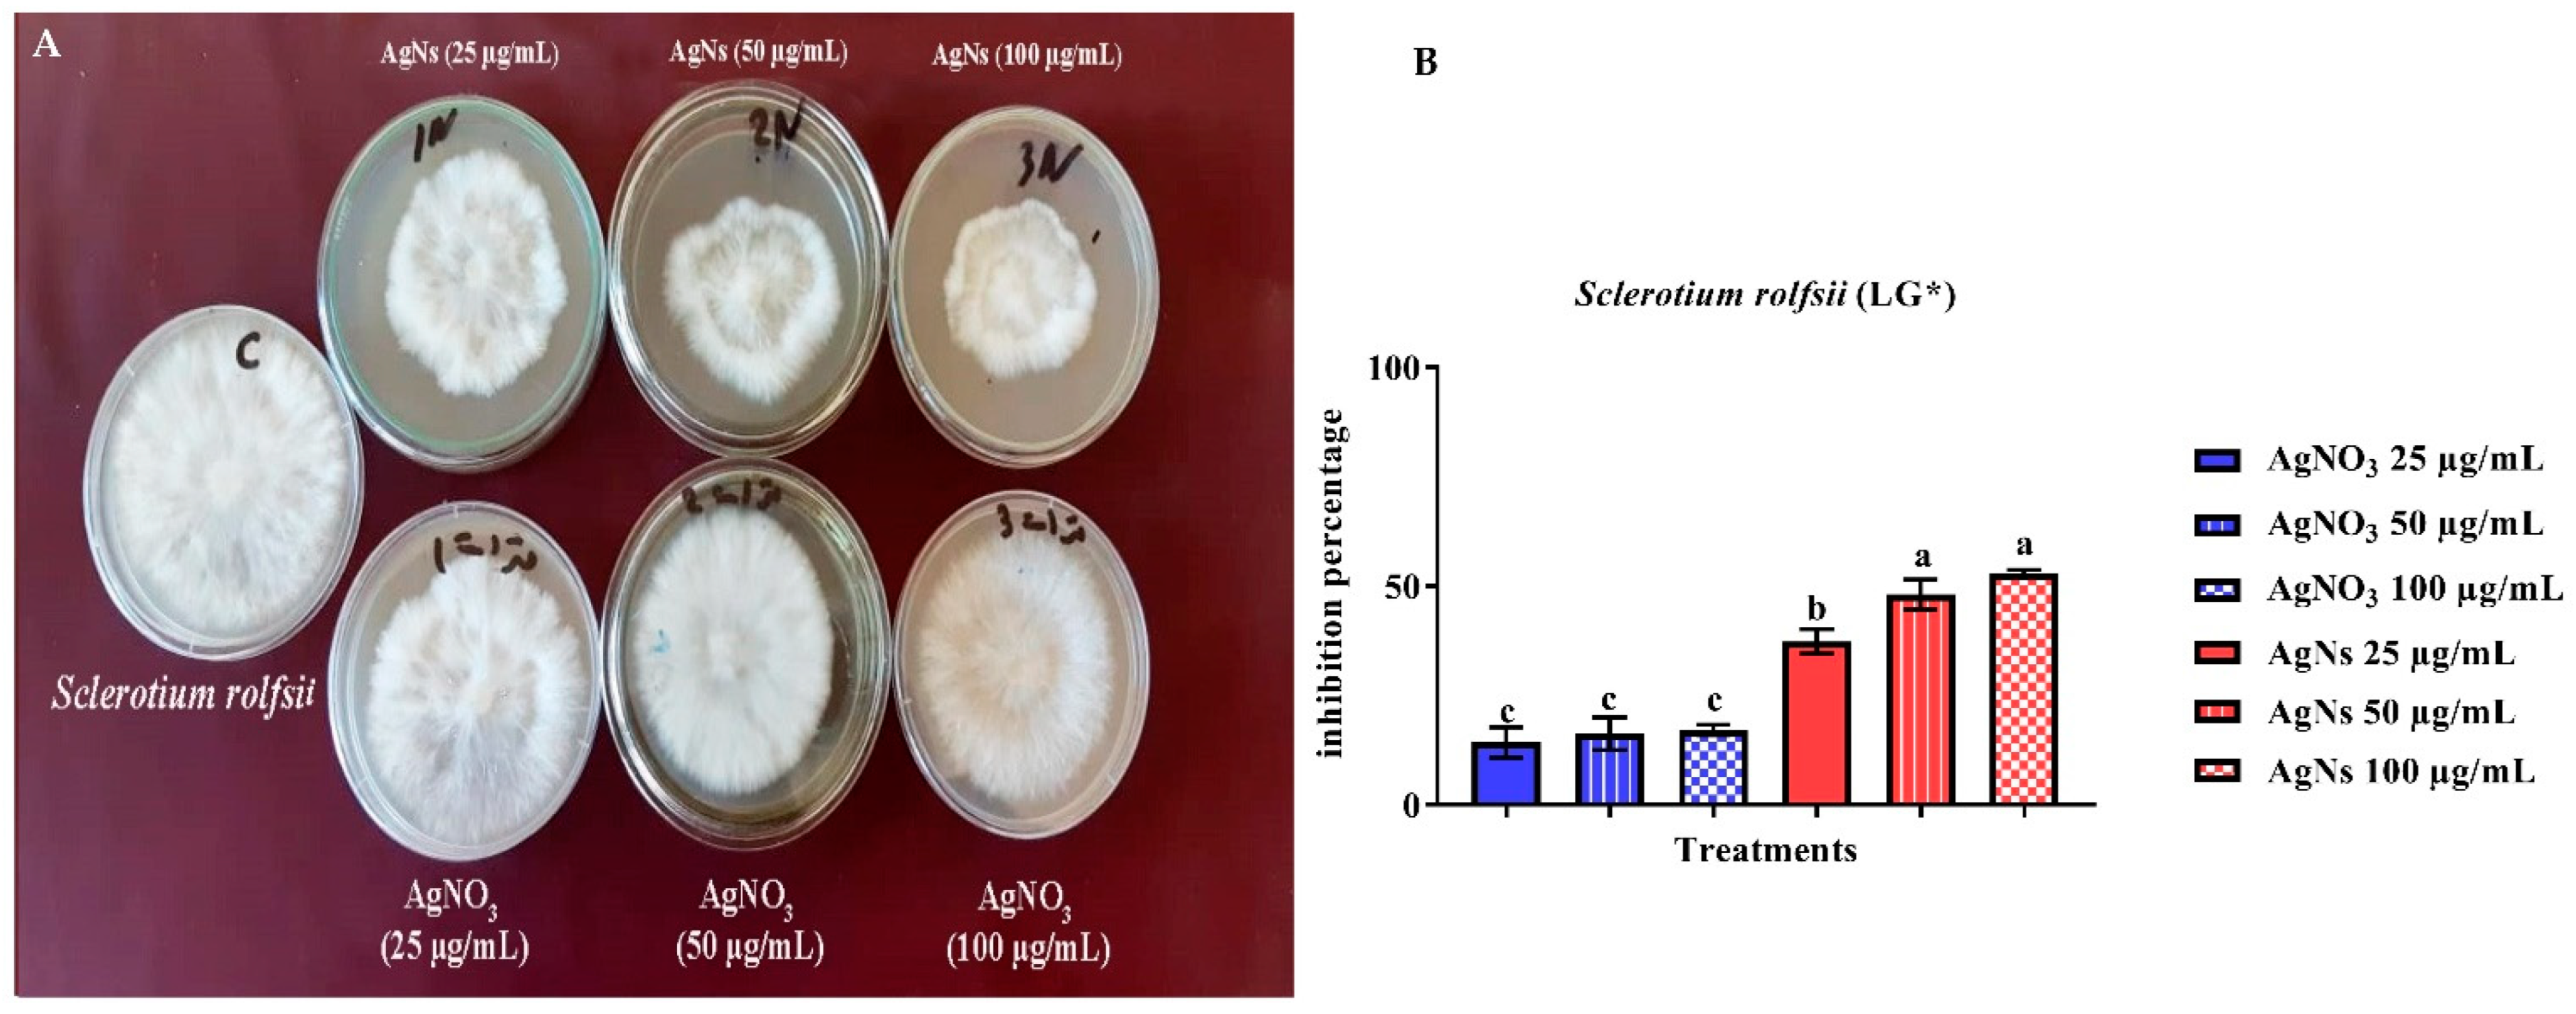
Jof 08 00597 g005

The Biogenically Efficient Synthesis of Silver Nanoparticles Using the Fungus Trichoderma harzianum and Their Antifungal Efficacy against Sclerotinia sclerotiorum and Sclerotium rolfsii
Abstract
:1. Introduction
2. Materials and Methods
2.1. Causal Agent and Bioagent
2.2. Extracellular Synthesis and Characterization of AgNs
2.3. Antifungal Activity of AgNs against S. sclerotiorum and S. rolfsii
2.3.1. Crude Culture Filtrate (CF)
2.3.2. Effect of AgNs on Some Growth Parameters of S. sclerotiorum and S. rolfsii
2.3.3. Effect of AgNs on the Mycelial Dry Weight of S. sclerotiorum and S. rolfsii
2.3.4. Effects of AgNs on Root and Crown Rot Severity Caused by S. sclerotiorum
2.3.5. Disease Assessment
2.4. In Vivo Effects of AgNs Foliar Spraying on Sunflower Plants Infected by S. rolfsii
2.5. Statistical Analysis
3. Results
3.1. Biosynthesis and Characterization of AgNs
3.2. Antifungal Activity of AgNs
3.2.1. In Vitro Effect of AgNs on the Growth of Sclerotinia sclerotiorum and Sclerotium rolfsii
3.2.2. Mycelial Dry Weight (DW)
3.2.3. Number of Sclerotia
3.2.4. In Vivo Effect of AgNs on the Severity of Root Rot Disease
4. Discussion
5. Conclusions
Author Contributions
Funding
Institutional Review Board Statement
Informed Consent Statement
Data Availability Statement
Conflicts of Interest
References
- Shang, Y.; Hasan, M.K.; Ahammed, G.J.; Li, M.; Yin, H.; Zhou, J. Applications of nanotechnology in plant growth and crop protection: A review. Molecules 2019, 24, 2558. [Google Scholar] [CrossRef] [PubMed] [Green Version]
- Sekhon, B.S. Nanotechnology in agri-food production: An overview. Nanotechnol. Sci. Appl. 2014, 7, 31–53. [Google Scholar] [CrossRef] [PubMed] [Green Version]
- Kalpana, V.N.; Devi-Rajeswari, V. A review on green synthesis, biomedical applications, and toxicity studies of ZnO NPs. Bioinorg. Chem. Appl. 2018, 2018, 3569758. [Google Scholar] [CrossRef]
- Guilger-Casagrande, M.; de Lima, R. Synthesis of silver nanoparticles mediated by fungi: A Review. Front. Bioeng. Biotechnol. 2019, 7, 287. [Google Scholar] [CrossRef] [Green Version]
- Ibrahim, K.; Khalid, S.; Idrees, K. Nanoparticles: Properties, applications and toxicities. Arab. J. Chem. 2019, 12, 908–931. [Google Scholar] [CrossRef]
- Ferdous, Z.; Nemmar, A. Health impact of silver nanoparticles: A review of the biodistribution and toxicity following various routes of exposure. Int. J. Mol. Sci. 2020, 21, 2375. [Google Scholar] [CrossRef] [PubMed] [Green Version]
- Elijah, A.; Adebayo, M.A.; Azeez, M.B.; Alao, A.M.; Oke, D.A. Fungi as veritable tool in current advances in nanobiotechnology. Heliyon 2021, 7, e08480. [Google Scholar] [CrossRef]
- Krishna, G.; Pranitha, V.; Singara, M.A. Biogenic synthesis of silver nanoparticles from white rot fungi: Their characterization and antibacterial studies. OpenNano 2017, 2, 64–78. [Google Scholar] [CrossRef]
- Guilger-Casagrande, M.; Germano-Costa, T.; Pasquoto-Stigliani, T.; Fraceto, L.F.; Lima, R. Biosynthesis of silver nanoparticles employing Trichoderma harzianum with enzymatic stimulation for the control of Sclerotinia sclerotiorum. Sci. Rep. 2019, 9, 14351. [Google Scholar] [CrossRef]
- Zin, N.A.; Badaluddin, N.A. Biological functions of Trichoderma spp. for agriculture applications. Ann. Agric. Sci. 2020, 65, 168–178. [Google Scholar] [CrossRef]
- Muhammad, T.; Tahir, F.; Ahmad, S.A.; Muhammad, D.H.; Amin, U.R. Role of Trichoderma as a biocontrol agent (BCA) of phytoparasitic nematodes and plant growth inducer. J. Invertebr. Pathol. 2021, 183, 107626. [Google Scholar] [CrossRef]
- Jorge, P. Trichoderma as biocontrol agent against pests: New uses for a mycoparasite. Biol. Control. 2021, 159, 104634. [Google Scholar] [CrossRef]
- Clarkson, J.P.; Staveley, J.; Phelps, K.; Young, C.S.; Whipps, J.M. Ascospore release and survival in Sclerotinia sclerotiorum. Mycol. Res. 2003, 107, 213–222. [Google Scholar] [CrossRef] [PubMed] [Green Version]
- Okabe, I.; Matsumoto, N. Phylogenetic relationship of Sclerotium rolfsii (teleomorph Athelia rolfsii) and S. delphinii based on ITS sequences. Mycol. Res. 2003, 107, 164–168. [Google Scholar] [CrossRef] [PubMed]
- EL-Ashmony, R.M.S.; Abdel-Latif, M.R.; Abdou, E.L.S.; Galal, A.A. Influence of hydrogen peroxide (H2O2) on Trichoderma harzianum potentiality to control sunflower root/collar rot pathogen Sclerotium rolfsii. Egypt. J. Phytopathol. 2017, 45, 103–113. [Google Scholar] [CrossRef]
- Chowdhury, S.; Basu, A.; Kundu, S. Green synthesis of protein capped silver nanoparticles from phytopathogenic fungus Macrophomina phaseolina (Tassi) Goid with antimicrobial properties against multidrug-resistant bacteria. Nanoscale Res. Lett. 2014, 9, 365. [Google Scholar] [CrossRef] [Green Version]
- Vinale, F.; Ghisalberti, E.L.; Sivasithamparam, K. Factors affecting the production of Trichoderma harzianum secondary metabolites during the interaction with different plant pathogens. Lett. Appl. Microbiol. 2009, 48, 705–711. [Google Scholar]
- EL-Bana, A.A.; Hassan, H.M.M.; Abdou, E.-S.; Galal, A.A. Effect of calcium salts on growth, sclerotia and infectivity of Sclerotinia sclerotiorum. Assiut J. Agri. Sci. 2006, 37, 175–187. [Google Scholar]
- Guilger-Casagrande, M.; Germano-Costa, T.; Bilesky-José, N. Influence of the capping of biogenic silver nanoparticles on their toxicity and mechanism of action towards Sclerotinia sclerotiorum. J. Nanobiotechnol. 2021, 19, 53. [Google Scholar] [CrossRef]
- Liu, S.; Wang, H.; Zhang, J. In vitro mutation and selection of doubled-haploid Brassica napus lines with improved resistance to Sclerotinia sclerotiorum. Plant Cell Rep. 2005, 24, 133–144. [Google Scholar] [CrossRef]
- Sharma, A.; Wray, V.; Johri, N.B. Rhizosphere Pseudomonas sp. strains reduce occurrence of pre- and post-emergence damping-off in chile and tomato in Central Himalayan region. Arch. Microbiol. 2006, 187, 321–335. [Google Scholar] [CrossRef] [PubMed]
- Wheeler, B.E.J. An Introduction to Plant Disease; John Wiley and Sons Ltd.: London, UK, 1969; 301p. [Google Scholar]
- El-Baky, N.A.; Amara, A.F. Recent approaches towards control of fungal diseases in plants: An Updated Review. J. Fungi 2021, 7, 900. [Google Scholar] [CrossRef] [PubMed]
- Abd EL-Razik, A.A.; Shatla, M.N.; Rushdi, M. Relationship of pectolytic enzymes production by isolates of S. cepivorum to their pathogenicity. Zentbl. Bakt. Parasitkde 1974, 129, 253–258. [Google Scholar]
- Kitching, M.; Ramani, M.; Marsili, E. Fungal biosynthesis of gold nanoparticles: Mechanism and scale up. Microb. Biotechnol. 2015, 8, 904–917. [Google Scholar] [CrossRef] [PubMed]
- Kim, S.H.; Lee, H.S.; Ryu, D.S.; Choi, S.J.; Lee, D.S. Antibacterial activity of silver-nanoparticles against Staphylococcus aureus and Escherichia coli. Korean J. Microbiol. Biotechnol. 2011, 39, 77–85. [Google Scholar]
- Fayaz, A.M.; Balaji, K.; Girilal, M.; Yadav, R.; Kalaichelvan, P.T.; Venketesan, R. Biogenic synthesis of silver nanoparticles and their synergistic effect with antibiotics: A study against gram-positive and gram-negative bacteria,” Nanomedicine: Nanotechnology. Biol. Med. 2010, 6, e103–e109. [Google Scholar] [CrossRef]
- Kim, S.W.; Jung, J.H.; Lamsal, K.; Kim, Y.S.; Min, J.S.; Lee, Y.S. Antifungal effects of silver nanoparticles (agnps) against various plant pathogenic fungi. Mycobiology 2012, 40, 53–58. [Google Scholar] [CrossRef] [Green Version]
- Dakal, T.C.; Kumar, A.; Majumdar, R.S.; Yadav, V. Mechanistic basis of antimicrobial actions of silver nanoparticles. Front. Microbiol. 2016, 7, 1831. [Google Scholar] [CrossRef] [Green Version]
- Sheikh, M.; Irfana, Z.; Rehman, B.T.; Padder, S.A.; Bhat, Z.A.; Mustafa, K.A.; Linghuo, J. Fabrication of silver nanoparticles against fungal pathogens. Front. Nanotech. 2021, 3, 679358. [Google Scholar] [CrossRef]
- Kim, H.S.; Kang, H.S.; Chu, G.J.; Byun, H.S. Antifungal effectiveness of nanosilver colloid against rose powdery mildew in greenhouses. Solid State Phenom. 2008, 135, 15–18. [Google Scholar] [CrossRef]
- Lamsal, K.; Kim, S.W.; Jung, J.H.; Kim, Y.S.; Kim, K.S.; Lee, Y.S. Inhibition effects of silver nanoparticles against powdery mildews on cucumber and pumpkin. Mycobiology 2011, 13, 26–32. [Google Scholar] [CrossRef] [PubMed] [Green Version]
- Park, H.-J.; Kim, S.H.; Kim, H.J.; Choi, S.-H. A new composition of nanosized silica-silver for control of various plant diseases. Plant Pathol. J. 2016, 22, 295–302. [Google Scholar] [CrossRef]
- Villaverde, J.J.; Sevilla-Morán, B.; López-Goti, C.; Alonso-Prados, J.L.; Sandín-España, P. Considerations of nano-QSAR/QSPR models for nanopesticide risk assessment within the European legislative framework. Sci. Total Environ. 2018, 634, 1530–1539. [Google Scholar] [CrossRef] [PubMed]

Publisher’s Note: MDPI stays neutral with regard to jurisdictional claims in published maps and institutional affiliations. |
© 2022 by the authors. Licensee MDPI, Basel, Switzerland. This article is an open access article distributed under the terms and conditions of the Creative Commons Attribution (CC BY) license (https://creativecommons.org/licenses/by/4.0/).
Share and Cite
El-Ashmony, R.M.S.; Zaghloul, N.S.S.; Milošević, M.; Mohany, M.; Al-Rejaie, S.S.; Abdallah, Y.; Galal, A.A. The Biogenically Efficient Synthesis of Silver Nanoparticles Using the Fungus Trichoderma harzianum and Their Antifungal Efficacy against Sclerotinia sclerotiorum and Sclerotium rolfsii. J. Fungi 2022, 8, 597. https://doi.org/10.3390/jof8060597
El-Ashmony RMS, Zaghloul NSS, Milošević M, Mohany M, Al-Rejaie SS, Abdallah Y, Galal AA. The Biogenically Efficient Synthesis of Silver Nanoparticles Using the Fungus Trichoderma harzianum and Their Antifungal Efficacy against Sclerotinia sclerotiorum and Sclerotium rolfsii. Journal of Fungi. 2022; 8(6):597. https://doi.org/10.3390/jof8060597
Chicago/Turabian StyleEl-Ashmony, Ranya M. S., Nouf S. S. Zaghloul, Marija Milošević, Mohamed Mohany, Salim S. Al-Rejaie, Yasmine Abdallah, and Anwar A. Galal. 2022. "The Biogenically Efficient Synthesis of Silver Nanoparticles Using the Fungus Trichoderma harzianum and Their Antifungal Efficacy against Sclerotinia sclerotiorum and Sclerotium rolfsii" Journal of Fungi 8, no. 6: 597. https://doi.org/10.3390/jof8060597
APA StyleEl-Ashmony, R. M. S., Zaghloul, N. S. S., Milošević, M., Mohany, M., Al-Rejaie, S. S., Abdallah, Y., & Galal, A. A. (2022). The Biogenically Efficient Synthesis of Silver Nanoparticles Using the Fungus Trichoderma harzianum and Their Antifungal Efficacy against Sclerotinia sclerotiorum and Sclerotium rolfsii. Journal of Fungi, 8(6), 597. https://doi.org/10.3390/jof8060597

